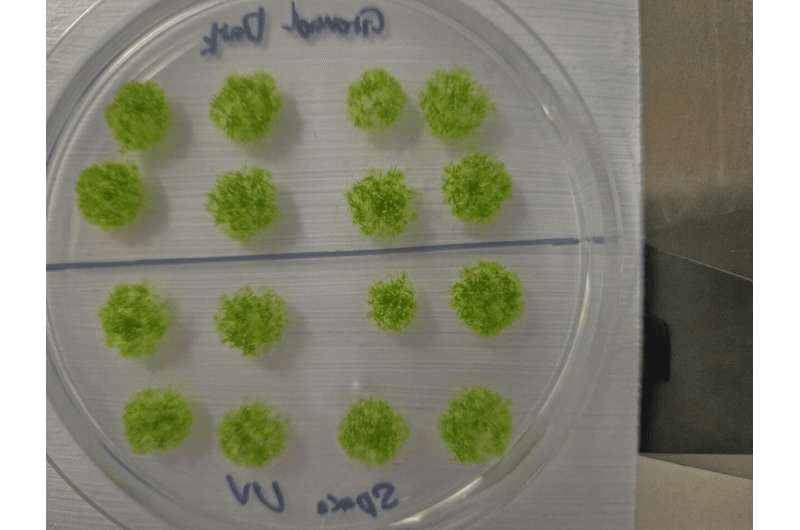

Los musgos prosperan en los entornos más extremos de la Tierra, desde las cumbres del Himalaya hasta las arenas del Valle de la Muerte, la tundra antártica y los campos de lava de los volcanes activos. Inspirados por la resistencia de los musgos, los investigadores enviaron esporofitos de musgo —estructuras reproductivas que contienen esporas— al entorno más extremo hasta la fecha: el espacio.
Sus resultados, publicados en la revista iScience el 20 de noviembre, muestran que más del 80% de las esporas sobrevivieron nueve meses fuera de la Estación Espacial Internacional (ISS) y regresaron a la Tierra aún capaces de reproducirse, demostrando por primera vez que una planta terrestre primitiva puede sobrevivir a una exposición prolongada a los elementos del espacio.
“La mayoría de los organismos vivos, incluidos los humanos, no pueden sobrevivir ni siquiera brevemente en el vacío del espacio”, afirma el autor principal, Tomomichi Fujita, de la Universidad de Hokkaido. “Sin embargo, las esporas de musgo conservaron su vitalidad tras nueve meses de exposición directa. Esto proporciona una prueba contundente de que la vida que ha evolucionado en la Tierra posee, a nivel celular, mecanismos intrínsecos para soportar las condiciones del espacio”.
A Fujita se le ocurrió la idea del musgo espacial mientras estudiaba la evolución y el desarrollo de las plantas. Le impresionó la capacidad del musgo para colonizar incluso los entornos más inhóspitos de la Tierra. “Empecé a preguntarme: ¿podría esta pequeña pero extraordinariamente resistente planta sobrevivir también en el espacio?”.
Para averiguarlo, el equipo de Fujita sometió a Physcomitrium patens, un musgo muy estudiado comúnmente conocido como musgo terrestre rastrero, a un entorno espacial simulado, que incluía altos niveles de radiación UV, temperaturas extremadamente altas y bajas, y condiciones de vacío.
Analizaron tres estructuras diferentes del musgo: protenemata, o musgo juvenil; células de cría, o células madre especializadas que surgen en condiciones de estrés; y esporofitos, o esporas encapsuladas, para averiguar cuál tenía la mejor oportunidad de sobrevivir en el espacio.
“Anticipábamos que las tensiones combinadas del espacio, incluyendo el vacío, la radiación cósmica, las fluctuaciones extremas de temperatura y la microgravedad, causarían daños mucho mayores que cualquier tensión individual”, dice Fujita.
Los investigadores descubrieron que la radiación UV era el elemento más difícil de sobrevivir, y que los esporofitos eran, con diferencia, la parte más resistente del musgo. Ninguno de los musgos jóvenes sobrevivió a altos niveles de radiación UV ni a temperaturas extremas. Las células germinativas presentaron una mayor tasa de supervivencia, pero las esporas encapsuladas mostraron una tolerancia a la radiación UV aproximadamente 1000 veces superior. Las esporas también lograron sobrevivir y germinar tras ser expuestas a −196°C durante más de una semana, así como después de permanecer a 55°C durante un mes.
El equipo sugirió que la estructura que rodea la espora actúa como una barrera protectora, absorbiendo la radiación ultravioleta y cubriendo la espora interna tanto física como químicamente para prevenir daños. Los investigadores señalan que probablemente se trate de una adaptación evolutiva que permitió a las briofitas —el grupo de plantas al que pertenecen los musgos— pasar de ser plantas acuáticas a terrestres hace 500 millones de años y sobrevivir a varias extinciones masivas desde entonces.
Para comprobar si esta adaptación podía hacer que los esporofitos fueran aptos para las condiciones reales del espacio, el equipo envió las esporas más allá de la estratosfera. En marzo de 2022, los investigadores enviaron cientos de esporofitos a la EEI a bordo de la nave espacial Cygnus NG-17. Una vez allí, los astronautas adhirieron las muestras de esporofitos al exterior de la EEI, donde estuvieron expuestas al espacio durante un total de 283 días. Posteriormente, el musgo regresó a la Tierra en la misión SpaceX CRS-16 en enero de 2023 y fue devuelto al laboratorio para su análisis.
“Esperábamos una supervivencia prácticamente nula, pero el resultado fue el opuesto: la mayoría de las esporas sobrevivieron”, afirma Fujita. “Nos asombró realmente la extraordinaria resistencia de estas diminutas células vegetales”.

Más del 80% de las esporas sobrevivieron a su viaje intergaláctico, y todas menos el 11% de las restantes lograron germinar en el laboratorio. El equipo también analizó los niveles de clorofila de las esporas y encontró niveles normales en todos los tipos, con la excepción de una reducción del 20% en la clorofila a, un compuesto particularmente sensible a los cambios en la luz visible, pero este cambio no pareció afectar la viabilidad de las esporas.
“Este estudio demuestra la asombrosa resiliencia de la vida que se originó en la Tierra”, afirma Fujita.
Intrigados por saber cuánto tiempo más podrían haber sobrevivido las esporas en el espacio, el equipo de Fujita utilizó datos previos y posteriores a la expedición del musgo para crear un modelo matemático. Predijeron que las esporas encapsuladas podrían haber sobrevivido hasta 5600 días —aproximadamente 15 años— en condiciones espaciales. Sin embargo, recalcan que esta cifra es sólo una estimación aproximada y que se necesita un conjunto de datos más amplio para realizar predicciones más realistas sobre cuánto tiempo podría sobrevivir el musgo en el espacio. Los investigadores esperan que su trabajo ayude a avanzar en la investigación sobre el potencial de los suelos extraterrestres para facilitar el crecimiento de las plantas e inspire la exploración del uso de musgos para desarrollar sistemas agrícolas en el espacio.
“En última instancia, esperamos que este trabajo abra una nueva frontera hacia la construcción de ecosistemas en entornos extraterrestres como la Luna y Marte”, afirma Fujita. “Espero que nuestra investigación sobre musgos sirva como punto de partida”.
Fuente: Phys.org.
